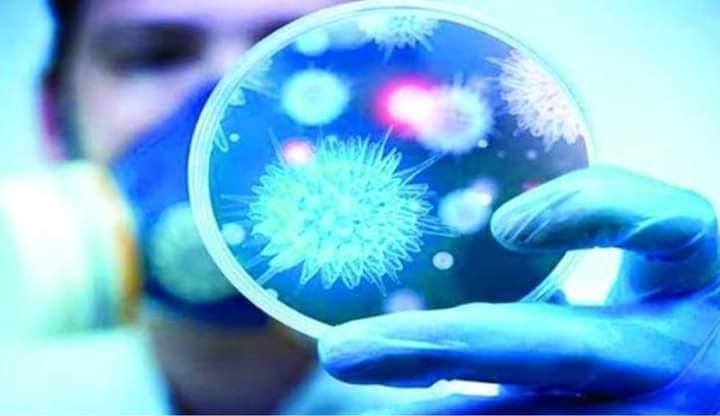

كتبت – فاطمة أنور
أعلنت الحكومة الأمريكية، من خلال الوكالة الأمريكية للتنمية الدولية، عن تقديم أكثر من 5 ملايين دولار كمساعدات عاجلة لمكافحة فيروس كورونا في مصر وذلك بالتعاون مع وزارتي التعاون الدولي والصحة والسكان.
وستدعم هذه المنحة العاملين بالقطاع الصحي في جهودهم لإعطاء اللقاح للمواطنين وتعزيز سلسلة توريد اللقاحات لضمان الوصول العادل لتلك اللقاحات في جميع أنحاء الجمهورية. حيث يعمل هذا التمويل أيضاً على تعزيز قدرة النظام الصحي في مصر على الحد من انتشار والكشف المبكر والاستجابة لـفيروس كورونا والمخاطر المستقبلية التي قد تُهدد الصحة العامة.
وصرّح السفير الأمريكي جوناثان كوهين، بأن “هذا الدعم الإضافي البالغ قيمته 5 ملايين دولار للاستجابة لفيروس كورونا يؤكد على الالتزام المستمر من جانب الحكومة الأمريكية في دعم مصر خلال الأزمة الصحية العالمية. لقد عملت الولايات المتحدة ومصر حكومةً وشعباً جنباً إلى جنب للتصدي لجائحة كوفيد-19 منذ بدايتها، حيث أرسلت مصر إمدادات طبية إلى الولايات المتحدة. وفي الأسبوع الماضي كان من دواعي سروري أن نكون في استقبال 1.6 مليون جرعة من لقاح فايزر.”
كما صرحت الدكتورة رانيا المشاط وزيرة التعاون الدولي، تعليقاً على المنحة المُقدمة للاستجابة العاجلة لجائحة كوفيد-19 بقيمة 5 مليون دولار: “انطلاقاً من التزام الحكومة المصرية بالعمل الجاد نحو التعافي، تعمل وزارة التعاون الدولي مع شركاء التنمية متعددي الأطراف والثنائيين للاستجابة للتداعيات السلبية التي شكّلتها الجائحة. وقد أثمر تعاون مصر مع الولايات المتحدة على إثراء الأجندة الوطنية، بما يتوافق مع أهداف التنمية المستدامة للأمم المتحدة، وتحديداً في قطاعات الصحة والتعليم وتمكين المرأة”.
من جانبها قالت الدكتورة هالة زايد وزيرة الصحة والسكان:”أود أن أتقدم بالشكر إلى حكومة الولايات المتحدة على الدعم والتعاون المستمر، بصفة خاصة خلال جائحة كوفيد-19. إننا نُثمّن التضامن الدولي خلال هذه الأزمة العالمية. وكنا قد تلقينا في الأسبوع الماضي الشحنة الأولى من جرعات لقاح فايزر المُهداة من الولايات المتحدة عن طريق آلية كوفاكس والتي ستساعد المصريين على البقاء بصحة جيدة خلال هذا الوقت العصيب. هناك تاريخ طويل من التعاون بين الوكالة الأمريكية للتنمية الدولية ووزارة الصحة والسكان في القطاع الصحي، وأنا أتطلع إلى مزيد من التعاون في السنوات القادمة”.
وقدّمت الحكومة الأمريكية، من خلال الوكالة الأمريكية للتنمية الدولية، حتى الآن أكثر من 55 مليون دولار من المساعدات المتعلقة باستجابة مصر لفيروس كورونا منذ بداية الجائحة في العام الماضي، حيث وفرت هذه المساعدات الدعم الصحي والاقتصادي الضروري لما يقرب من 18 مليون مواطن. وتوفر برامج الوكالة الأمريكية للتنمية الدولية التدريب للعاملين في مجال الرعاية الصحية، وتعزز أنظمة التتبع والاستجابة للجائحة، وتقدّم مساعدات غذائية للأسر المتضررة من الآثار الناجمة عن الجائحة، كما توفر الدعم للمشروعات الصغيرة. ويأتي دعم الوكالة الأمريكية للتنمية الدولية لجهود الاستجابة لفيروس كورونا استكمالاً لاستثمارات الحكومة الأمريكية على مدار الأربعين عاماً الماضية والتي بلغت قيمتها أكثر من مليار دولار لتحسين صحة جميع المصريين.

المزيد من القصص
تعاون مصرى أمريكي لاسترداد 13قطعة آثرية تنمتي إلي عصور تاريخية مختلفة من الحضارة المصرية القديمة
صرخة من داخل المستشفى إختفاء رضيعة بعد ساعات من ولادتها في الحسين الجامعي يهز القلوب
مطار القاهرة الدولي يحتفل بأعياد الربيع مع الركاب